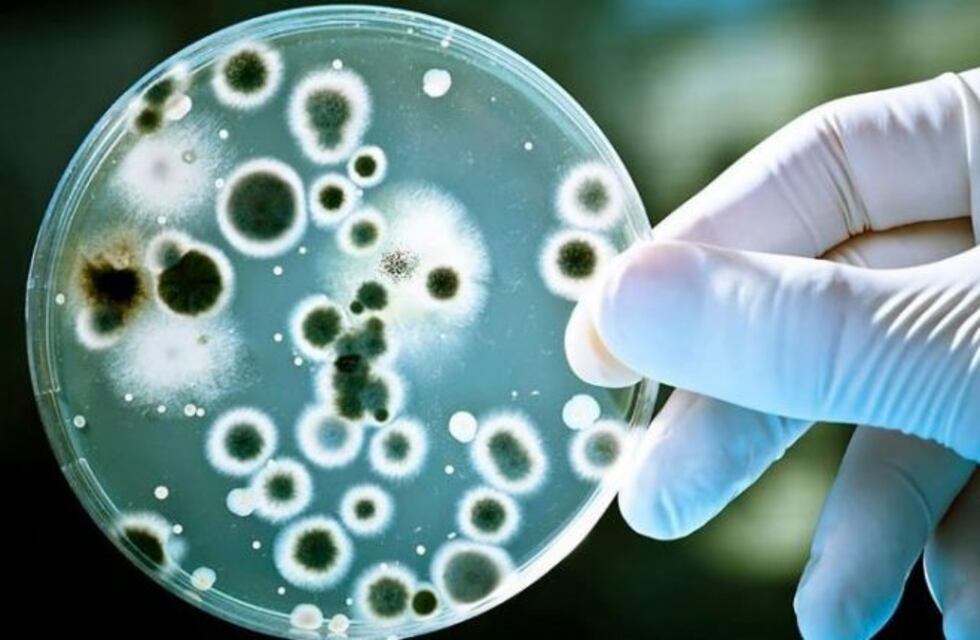

La muerte de seis personas por cuadros invasivos de la bacteria estreptococo pyogenes encendió la alarma, por lo que en estos momentos se está llevando adelante en el instituto de referencia ANLIS – Malbrán la investigación de la cepa que está circulando, para determinar si efectivamente se trata de una cepa más virulenta.
Según consignó Clarín, en el instituto hay tres equipos de profesionales abocados a esa tarea: el de Bacteriología especial, el de Resistencia antimicrobiana y el equipo de Plataforma de Genoma y bioinformática. Los equipos harán la secuenciación completa del genoma de la bacteria que permitirá identificar si se trata de una cepa más virulenta.
A su vez, se realizará un perfil de respuesta o resistencia a los distintos agentes antimicrobianos o antibióticos. Esto es clave para determinar el mejor tratamiento de los casos.

"Suponemos que es la cepa agresiva, pero para poder confirmarlo se mandó a estudiar la cepa al Instituto Malbrán, que nos va a caracterizar algunas proteínas que las hace más virulentas. Sospechamos que puede tener esa virulencia", dijo este miércoles el doctor Angel Cancellara, jefe de infectología del Hospital Elizalde, donde todavía hay dos niños internados por cuadros invasivos de estreptococo y que evolucionan favorablemente.
"A través del laboratorio de referencia vamos a saber qué está pasando con la cepa. El año pasado hubo una situación parecida en Neuquén, donde se presentó también un grupo de casos, pero finalmente se determinó que era la misma cepa", señaló Patricia Angeleri, directora de Epidemiología de la Secretaría de Salud de la Nación.
"Más allá de la cepa –añadió la especialista-, la bacteria es sensible a la penicilina. Si surgiera alguna característica particular la vamos a notificar a los equipos de salud".